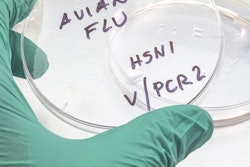
Avian Flu

A newly published invited review in the Journal of Dairy Science presents a comprehensive look at the effects of H5N1 virus and calls for a One Health approach in response.
With current science pointing to complex transmission dynamics and broad consequences, the authors argue that only a One Health approach, taking into account the intersection of animal and human health with that of the environment, can effectively combat H5N1 and prevent future outbreaks.
“The H5N1 outbreak in dairy cattle is unlike anything we have seen before – it has an exceptional ability to spread between farms and among cows within a farm – and is the first time an infectious disease of this magnitude has affected the U.S. dairy sector in nearly 100 years. It has revealed challenges we still haven’t solved in our ability to detect, report and manage new diseases,” said Jason Lombard, DVM, MS, of Colorado State University, lead author of the review.
The review, building on the current body of literature and best firsthand accounts and unpublished data of the outbreak, describes how the H5N1 virus, previously known for outbreaks in poultry, spilled over from wild birds into dairy herds and a range of other animal species, and maps the broad impacts of the virus to date.
“Our team wanted to describe the effects of H5N1 (on) agriculture as well as animal and human health in the U.S. and demonstrate that a One Health perspective – or one that takes the health of animals, humans and the environment as a holistic interconnected network into account – will be essential to navigating this outbreak,” Lombard said.
Stopping the spread of H5N1 starts with an understanding of exactly how the virus spilled over into cattle, and the routes it is taking to spread among dairy cattle and between farms – both of which are still unknown. The evidence suggests that cows’ initial exposure may occur through feed or water contaminated by wild birds, although it is possible the virus could also spread through aerosols (tiny airborne particles) or via fomites (contaminated surfaces or objects). After their initial exposure, cows can easily spread the virus to others in their herd.
Lombard and the report’s co-authors are clear that understanding transmission will be critical to stopping the spread of H5N1, and that this is uniquely challenging because of the structure and complexity of the dairy industry in which cattle, humans, other animals and equipment are frequently in close contact and moved from location to location.
“Overall, it’s important to think of our dairy operations as ecosystems,” said co-author Brian McCluskey, DVM, PhD, DACVPM, of Colorado State University. “It’s not just cows that make up a dairy farm, but a dynamic and interconnected community of living organisms – birds, cats, flies and people – as well as their physical environments – water, vehicles, bedding, housing and equipment.”
All of these interact with each other to potentially spread pathogens including H5N1, which is why tracking, understanding and mitigating the virus is complicated and will require the collaboration of multiple partners: producers, herd veterinarians, government and state partners, and researchers.
The human element of this outbreak is the final area the team reviewed, touching on the impact on human health to date and the potential for a larger H5N1 human pandemic in the future.
The report’s authors said controlling the spread of H5N1 will demand a coordinated effort across the dairy sector to strengthen biosecurity practices on farms (including the role of dairy workers), broad viral surveillance and reporting, a review of current control measures, and potentially a vaccination option – all while protecting the livelihoods of dairy producers.